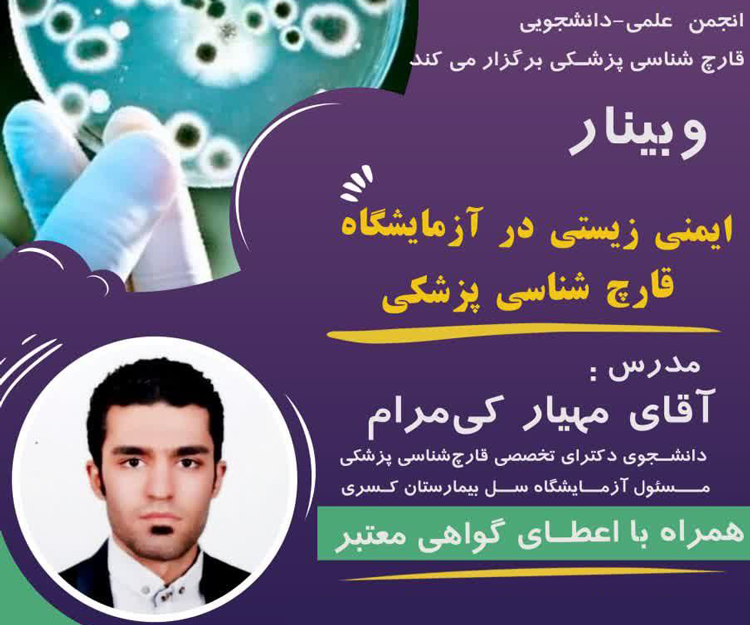
وبینار «ایمنی زیستی در آزمایشگاه قارچ‌شناسی پزشکی» همراه با اعطای گواهی

وبینار «ایمنی زیستی در آزمایشگاه قارچشناسی پزشکی» همراه با اعطای گواهی
انجمن علمی دانشجویی قارچشناسی پزشکی دانشگاه تربیت مدرس، ۲۱ شهریور ۱۴۰۲ از ساعت ۹ الی ۱۱، وبینار «ایمنی زیستی در آزمایشگاه قارچشناسی پزشکی» برگزار میکند. مدرس این وبینار مهیار کیمرام است و به شرکتکنندگان گواهی اعطا میشود.
علاقمندان جهت ثبتنام رایگان و دریافت لینک وبینار به رایانامه زیر پیام بفرستید: TMUMedicalmycology@gmail.com |